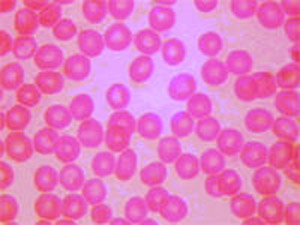
骨髓-胰腺綜合徵

疾病概述
骨髓-胰腺綜合徵又稱為Pearson綜合徵,是一種線粒體病,由於線粒體DNA的重大缺失(或重排)造成先天性漸進的多系統損害作為該病多系統疾病的一部分,患者早期即發生嚴重貧血骨髓中出現環形鐵粒幼細胞。本病的遺傳特性尚未定論近來報告在一對患本病的兄弟中發現有多發性的線粒體DNA缺失。提示本病屬常染色體顯性遺傳。也有人認為是紅細胞酶有缺陷所致。流行病學:嬰幼兒發病。
疾病病因
病因:常染色體顯性遺傳,紅細胞酶缺陷。
發病機制:是由於線粒體DNA的重大缺乏或重排所致。
臨床表現
 肝腎
肝腎疾病診斷
貧血
貧血鑑別診斷:
本病需與地中海貧血鑑別。而地中海貧血患者可同時伴發鐵粒幼細胞貧血。由於珠蛋白合成顯著減少多餘的血紅素可反饋抑制ALA合成酶,導致鐵粒幼細胞貧血。
與原發性鐵粒幼細胞貧血相鑑別
原發性鐵粒細胞貧血又叫“特發性鐵粒細胞貧血”、“難治性幼紅細胞貧血”或“原發性難治性鐵粒幼細胞貧血”。本病與遺傳無關。紅血病和白血病前期患者的骨髓中有時可出現較多鐵粒幼細胞或典型的鐵粒幼細胞貧血,故與骨髓增生性疾病的關係較密切。患者紅細胞中的游離原卟啉(FEP)常有輕度至中度增高,提示血紅素合成酶的活力有缺陷。採用放射化學研究顯示,多數病例骨髓中血紅素合成酶和氨基-γ-酮戊酸(ALA)合成酶的活力均減低。
約有40%病人可有肝脾腫大。晚期可出現血色病的表現。血象和骨髓象與遺傳性病例相似,但骨髓內有鐵粒環的鐵粒幼細胞可達43%-95%,鐵粒環在早期幼紅細胞中亦常出現,鐵粒細胞較多見。游離原卟啉大多中等度增多,偶見顯著增多(46-300μg/dl,正常16-36μg/dl)。游離糞卟啉增多或正常。白細胞和血小板計數正常或減低。約半數病人中性粒細胞的鹼性磷酸酶減少。紅細胞動力學的研究顯示,紅細胞無效性生成顯著。
與繼發性鐵粒幼發細胞貧血相鑑別
某些藥物或化學毒物可引起鐵粒幼細胞貧血稱為繼發性鐵粒幼發細胞貧血。其中主要有抗結核藥異煙肼、環絲氨酸及吡嗪醯胺,它們都有抗吡哆醇(維生素B6)的作用,從而抑制血紅素的生物合成而引起鐵粒幼細胞貧血。這些藥物連續用4~6周后,在極少數病人中可發生鐵粒幼細胞貧血,貧血程度中等,但停藥後貧血能逐漸減輕以至消失。
疾病檢查
 外周血
外周血1.外周血血紅蛋白減低,低色素性貧血的特徵很明顯,血塗片紅細胞形態常呈雙向即可見形態正常和不正常的兩類細胞。紅細胞明顯大小不均;異形、靶形橢圓形和點彩紅細胞增多網織紅細胞減少。白細胞及血小板數減少。紅細胞的滲透脆性呈明顯不一致性,可增高亦可降低。
2.骨髓像骨髓中紅系細胞過度增生,鐵染色顯示含鐵血黃素顯著增多,鐵粒幼細胞增至80%~90%,並可見到約10%~40%的環形鐵粒幼細胞,後者大多為中晚幼紅細胞。血塗片中亦可發現鐵粒幼細胞。偶爾出現巨幼樣紅細胞,可能為伴有葉酸缺乏。
3.血清鐵大多增高鐵飽和度常顯著增加鐵動力學研究通常顯示血漿鐵清除率加快,為正常的1/4~1/2;鐵利用率減低,約為正常的1/5~1/3。
4.紅細胞內FEP減少或在正常下線紅細胞內FEC大多正常。吡哆醇治療無效的病例,FEC可很高而FEP顯著減少。用51Cr測出的紅細胞生存時間正常或稍縮短紅細胞平均壽命40~100天。
5.一些患者在色氨酸負荷加重時尿中黃尿酸(4,8-二羥基喹林甲酸)和(或)犬尿喹啉酸的排泄增加,表示色氨酸的代謝異常。
其它輔助檢查:
1.肝活檢顯示鐵質沉積,不輸血者之肝臟也可有同樣的改變,常伴無症狀的細小結節狀肝硬化,與遺傳性血色病的肝臟病變很相似。
2.根據病情、臨床表現、症狀、體徵選擇心電圖、B超、X線等檢查。
相關檢查:
1、葉酸
檢查名稱:葉酸
別名:FA
正常值:
新生兒:15.9~72.5nmol/L(7~32ng/ml)
成人:4.1~20.4nmol/L(1.8~9.0ng/ml)
>60歲:4.5~27.2nmol/L(2~12ng/ml)
臨床意義:
(1)升高:使用葉酸製劑、VB12缺乏症、先天性葉酸代謝異常、惡性貧血等。
(2)降低:巨幼紅細胞性貧血、葉酸缺乏症。
葉酸缺乏的病因分類:
(1)葉酸攝入不足:酒精中毒偏食,牛奶哺乳,不適當的調理。
(2)葉酸吸收障礙:
①吸收不良綜合徵:原發性(特發性脂肪瀉、熱帶性斯潑盧、小兒脂肪瀉)、繼發性(胃或腸切除術後、盲管、吻合口狹窄、惡性腫瘤)先天性葉酸吸收障礙。
②腸道內細菌競爭:胃切除後遺症、小腸切除吻合口狹窄。
③葉酸吸收障礙:抗痙劑、抗癆藥等。
(3)葉酸需要量增加或利用障礙:
①需要量增加:妊娠分娩、溶血性貧血、惡性腫瘤、骨髓纖維化、風濕性關節炎、甲狀腺功能亢進等)。
②利用障礙:葉酸拮抗藥、VB12缺乏症、肝損害、先天性酶缺乏症等。
2、尿酸
檢查名稱:尿酸
別名:血清尿酸;UA
正常值:
磷鎢酸鹽法健康搜尋:
成人:男268~488μmol/L(4.5~8.2mg/dl)
女178~387μmol/L(3.0~6.5mg/dl)
>60歲男:250~476μmol/L(4.2~8.0mg/dl)
女:190~434μmol/L(3.2~7.3mg/dl)
尿酸酶法:
兒童:119~327μmol/L(2.0~5.5mg/dl)
成人:男208~428μmol/L(3.5~7.2mg/dl)
女155~357μmol/L(2.6~6.0mg/dl)
臨床意義:
(1)升高:
①尿酸產生過多:
A.原發性嘌呤生成亢進型、痛風。
B.環境與因素:
a.高嘌呤和高核酸飲食所致。
b.高蛋白飲食、酒精性飲料過量。
C.酶異常:
a.PRPP(磷酸核糖焦磷酸合成)活性亢進型
b.HGPRT(次黃嘌呤鳥嘌呤轉磷酸核糖基酶)部分缺乏型
D.繼發性嘌呤合成亢進:
a.葡萄糖-6-磷酸酶缺乏症
b.HGPRT(次黃嘌呤鳥嘌呤轉磷酸核糖基酶)完全缺乏(Lesch-Nyhan綜合徵)。
c.核糖循環亢進,使尿酸產生過剩:紅細胞增多症、白血病、多發性骨髓瘤、溶血性貧血、乾癬。
②尿酸排泄減少:
A.原發性尿酸排泄減低。
B.腎臟尿酸排泄減低:
a.腎功能減退:慢性腎炎、黏液性水腫、甲狀旁腺功能亢進症等。
b.尿酸分泌不減低、但再吸收增加:急性酒精中毒、妊娠中毒症、飢餓、糖尿病酮症酸中毒、1型糖尿病、Pownl伸舌樣痴呆綜合徵等。
c.藥物:速尿利尿酸、腫瘤化療藥物、左鏇多巴、苯妥英鈉甲基多巴等。
(2)降低:
①原發性低尿酸血症:
A.分泌前再吸收缺乏型
B.分泌後再吸收缺乏型。
C.二者均再吸收缺乏型。
D.分泌亢進型。
②繼發性低尿酸血症:
A.尿酸排泄劑。
B.腎小管酸中毒:Wilson病(肝豆狀核變性)、胱氨酸尿症、重金屬中毒、Fanconi(范孔尼)綜合徵(家族性少年型腎病綜合徵)、霍奇金病、支氣管癌等
C.嘌呤和尿酸生成低下:重症肝損害、黃嘌呤尿症、KRPP(磷酸核糖焦磷酸)合成酶缺乏症。
D.造影劑
③原因不明的低尿酸血症:Hartnup綜合徵(先天性色氨酸缺陷綜合徵)、惡性貧血、急性紫質症17-羥基化酶缺乏症、SIADH等。
④藥物性:辛可芬利尿劑、吲哚美辛、皮質類固醇、ACTH、大量水楊酸鹽等。
4、肌氨酸酐
檢查名稱:肌氨酸酐
別名:血清肌酐;Cr
正常值:
Jaffe連續監測或酶法:
臍帶:53~106μmol/L(0.6~1.2mg/dl)
兒童:27~62μmol/L(0.3~0.7mg/dl)
成人:男53~106μmol/L(0.6~1.2mg/dl)
女44~97μmol/L(0.5~1.1mg/dl)
Jaffe手工法抅:70~133μmol/L(0.8~1.5mg/dl)
臨床意義:
(1)升高:
①GFR(腎小球濾過率)減低:腎疾病、腎功能不全、心功能不全、脫水等。
②血液濃縮(多伴有GFR減低):脫水燒傷、惡病質、休克等。
③肌量增加:肢端肥大症、巨人症。
④其他:甲狀腺功能減低。
(2)降低:
肌萎縮肌營養不良、血液稀釋、輸液過量。
5、血小板
檢查名稱:血小板
別名:血小板數;PC;PLT
正常值:
顯微鏡計數法、血細胞自動計數儀:(100~300)×109/L(10萬~30萬/mm3)
臨床意義:
(1)減少:
①生成降低:再生障礙性貧血、急性白血病、淋巴肉瘤、霍奇金病、巨幼紅細胞性貧血、癌症骨髓轉移、藥物引起的骨髓抑制等。
②破壞亢進:
A.免疫性:特發性血小板減少性紫癜(ITP)、膠原性疾病淋巴增生性疾病、藥物等。
B.血栓形成或微小循環障礙:血栓性血小板減少性紫癜(TTP)、溶血性尿毒症綜合徵、彌散性血管內凝血(DIC)等
③分布異常:脾功能亢進症(班替綜合徵高雪病、肝硬化、淋巴瘤、結節病、黑熱病等)。
(2)增多:
①腫瘤性:特發性血小板增多症慢性粒細胞性白血病、真性紅細胞增多症、骨髓纖維化、淋巴網狀細胞瘤。
②反應性火罐網:出血、脾切除手術後、惡性腫瘤等。
6、血清鐵
檢查名稱:血清鐵
別名:SI
正常值:
比色法:
成人:男8.95~28.64μmol/L(50~160μg/dl)
女7.16~26.85μmol/L(40~150μg/dl)
新生兒:17.90~44.75μmol/L(100~250μg/dl)
嬰兒:7.16~17.90μmol/L(40~100μg/dl)
兒童:8.95~21.48μmol/L(50~120μg/dl)
7、血紅蛋白
檢查名稱:血紅蛋白
別名:Hb
正常值:
血細胞自動分析儀、氰化高鐵血紅蛋白法:
初生兒:180~190g/L(18~19g/dl)
成人:男性120~160g/L(12~16g/dl)
女性110~150g/L(11~15g/dl)
臨床意義:
(1)增多:
①生理性變化:新生兒高山地區居民、劇烈體力勞動或體育運動、超力型人等。
②病理性變化:
A.紅細胞增多症(繼發性或相對性):大量脫水所致血液濃縮(劇烈嘔吐、頻繁腹瀉、多汗、多尿、嚴重灼燒、長期禁食者)、機體長期缺氧(紫紺型先天性心臟病、肺源性心臟病、慢性高山病、嚴重肺氣腫)、慢性一氧化碳中毒等
B.真性紅細胞增多症。
(2)減少:
①生理性變化:妊娠中後期的稀血症。
②病理性變化:
A.失血性貧血:內臟出血、血友病血小板減少性紫癜等。
B.溶血性貧血:先天性溶血性貧血(地中海貧血蠶豆病、先天性非球形紅細胞貧血、先天性溶血性黃疸等),後天獲得性貧血(自身免疫性溶血性貧血、新生兒溶血病、陣發性睡眠性血紅蛋白尿、紅細胞碎片綜合徵、藥物性溶血性貧血:奎寧、奎尼丁、非那西丁等,藥物性溶血性貧血:苯、鉛砷等,感染性溶血性貧血)等火罐網
C.造血不良性貧血:缺鐵性貧血、惡性貧血、營養不良性貧血、再生障礙性貧血等。
8、鐵染色
檢查名稱:鐵染色
正常值:
(1)細胞外鐵:+~++
(2)細胞內鐵:鐵粒幼細胞19%~44%(占幼紅細胞比例)。
臨床意義:
(1)細胞內外鐵減少:缺鐵性貧血。
(2)鐵粒幼紅細胞增多:鐵粒幼紅細胞性貧血、溶血性貧血、巨幼紅細胞性貧血、多次輸血。
(3)細胞外鐵減少:血色病、尿毒症肝硬化、感染。
治療方案
本病缺乏有效的治療方法。
預後預防
預後多較差。病變程度較輕者生存期較長有人報導20歲以上仍生存者其貧血可恢復。
